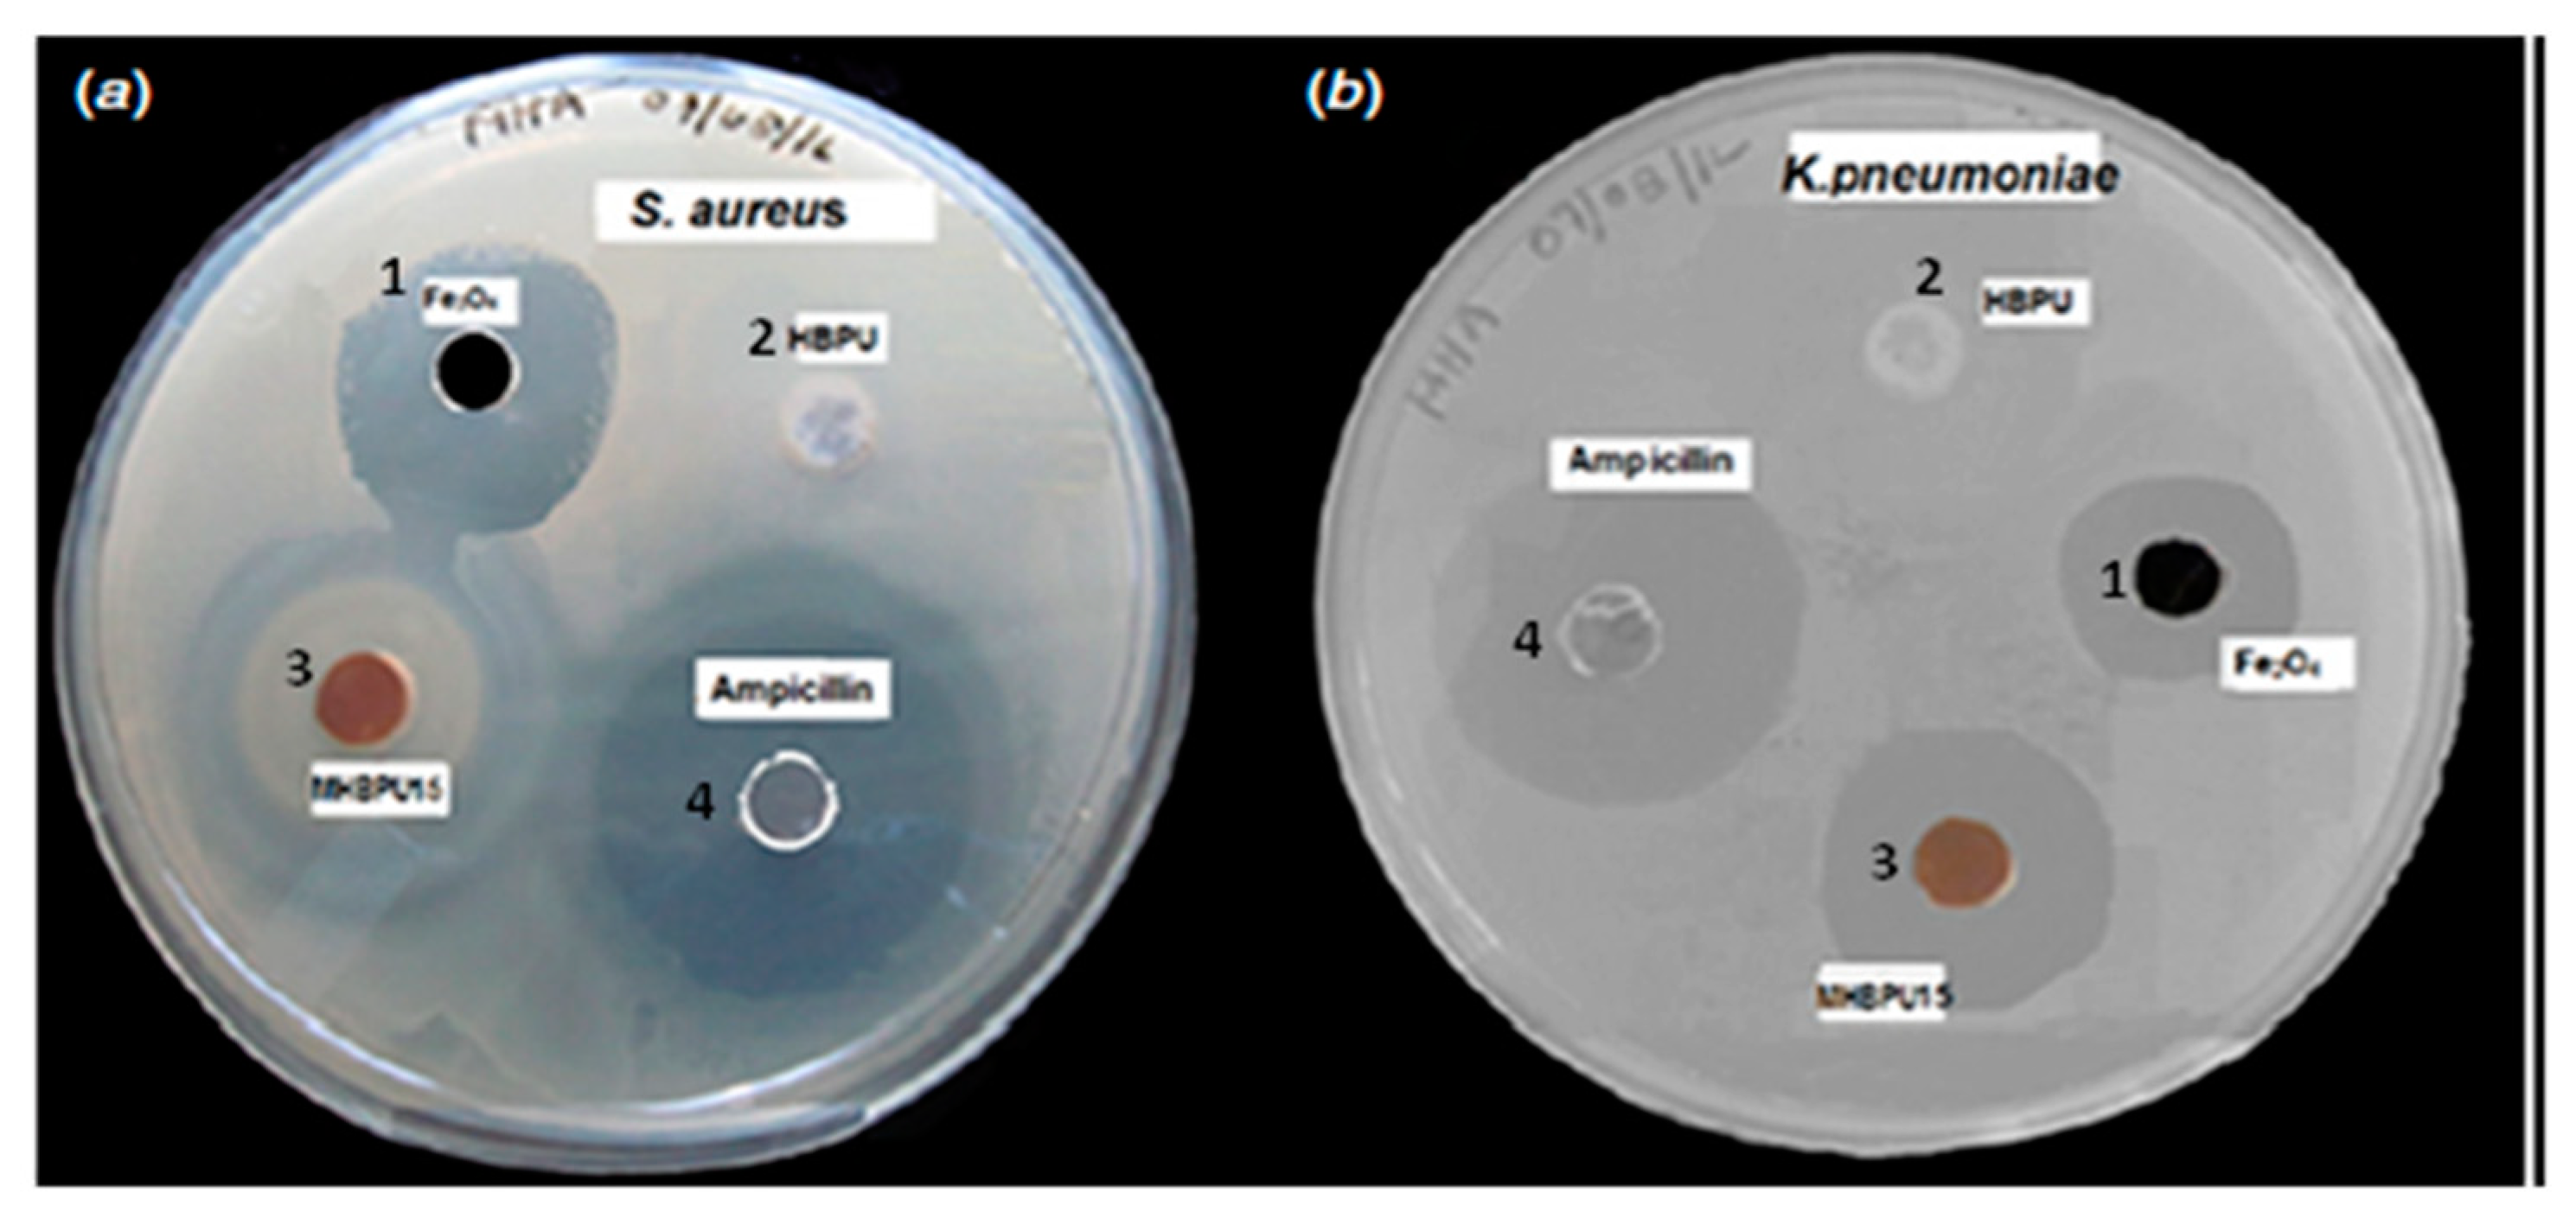
Polymers 11 01790 g013
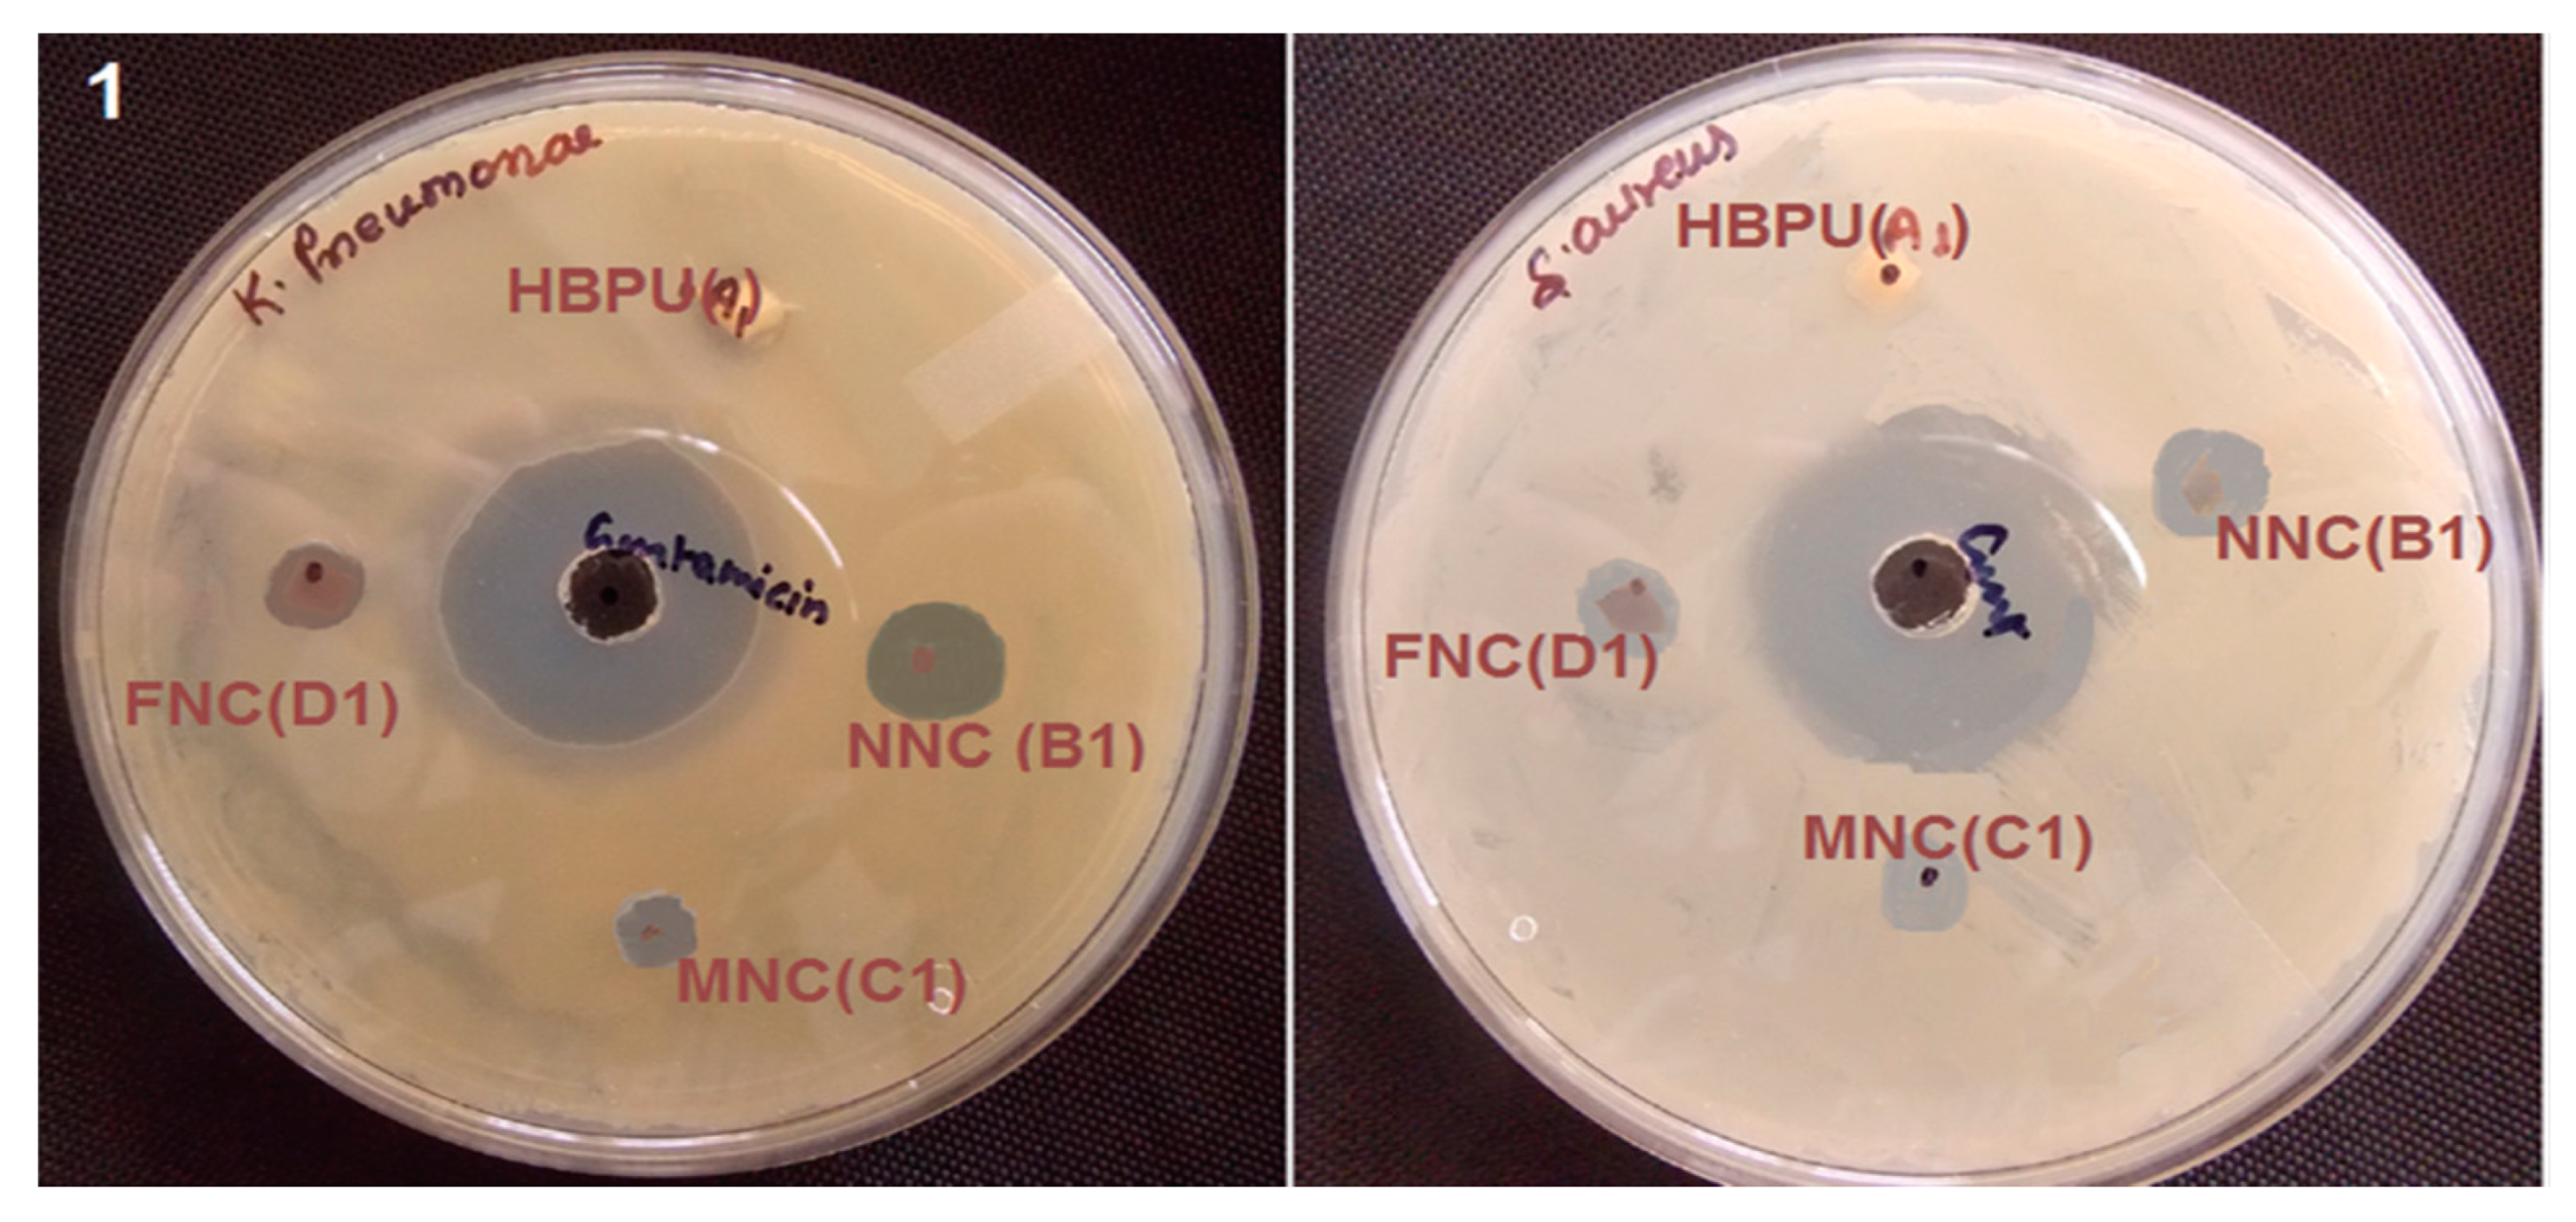
Polymers 11 01790 g014

Antibacterial Nanocomposites Based on Thermosetting Polymers Derived from Vegetable Oils and Metal Oxide Nanoparticles
Abstract
:1. Introduction
1.1. Thermosetting Polymers Obtained from Vegetable Oils
1.2. Antimicrobial Effect of Metal-Oxide Nanoparticles
1.2.1. Antimicrobial Effect of Zinc Oxide
1.2.2. Antimicrobial Effect of Titanium Oxide
1.2.3. Antimicrobial Effect of Copper Oxide
1.2.4. Antimicrobial Effect of Iron Oxide
2. Preparation of Vegetable Oil-Based Thermosetting Polymers Incorporating Metal Oxide Nanoparticles
2.1. Synthesis of Acrylated Epoxidized Linseed Oil (AELO)/TiO2 Nanocomposites
2.2. Synthesis of Crosslinked Castor Oil (CO)/Chitosan-Modified ZnO Nanoparticles (CS-ZnO NPs)
2.3. Synthesis of Epoxidized Soybean Oil (ESO)/ZnO Nanocomposites
2.4. Synthesis of Geranium-Derived Oil (Ge)/ZnO Nanocomposites
2.5. Synthesis of Sunflower Oil Derived Hyperbranched Polyurethane (HBPU)/Fe3O4 Nanocomposites
2.6. Synthesis of Linseed Oil (LO) Derived Polyol/CuO Nanocomposites
3. Morphology of Vegetable Oil-Based Thermoset Polymers with Metal Oxide Nanoparticles
3.1. Linseed Oil-Based Nanocomposites
3.2. Castor Oil-Based Nanocomposites
3.3. Soybean Oil-Based Nanocomposites
3.4. Geranium Oil-Based Nanocomposites
3.5. Sunflower Oil-Based Nanocomposites
4. Antimicrobial Activity of Vegetable Oil-Based Thermoset Polymers with Metal Oxide Nanoparticles
4.1. Antimicrobial Effect of Zinc Oxide-Reinforced Nanocomposites
4.2. Antimicrobial Effect of Titanium Oxide-Reinforced Nanocomposites
4.3. Antimicrobial Effect of Copper Oxide-Reinforced Nanocomposites
4.4. Antimicrobial Effect of Iron Oxide-Reinforced Nanocomposites
5. Conclusions
Acknowledgments
Conflicts of Interest
References
- Lligadas, G.; Ronda, J.C.; Galià, M.; Cádiz, V. Renewable polymeric materials from vegetable oils: A perspective. Mater. Today 2013, 16, 337–343. [Google Scholar] [CrossRef]
- Babu, R.P.; O’Connor, K.; Seeram, R. Current progress on bio-based polymers and their future trends. Prog. Biomater. 2013, 2, 8. [Google Scholar] [CrossRef] [PubMed] [Green Version]
- Raquez, J.-M.; Deléglise, M.; Lacrampe, M.-F.; Krawczak, P. Thermosetting (bio)materials derived from renewable resources: A critical review. Prog. Polym. Sci. 2010, 35, 487–509. [Google Scholar] [CrossRef]
- Gunstone, F. Fatty Acid & Lipid Chemistry; Blackie Academic & Professional: New York, NY, USA, 1996; pp. 1–252. ISBN 978-1-4613-6852-6. [Google Scholar]
- Belgacem, M.N.; Gandini, A. Monomers, Polymers and Composites from Renewable Resources; Elsevier: Amsterdam, The Netherlands, 2008; pp. 39–66. ISBN 9780080453163. [Google Scholar]
- Allen, R.R.; Formo, M.V.; Krishnamurthy, R.G.; McDermott, G.N.; Norris, F.A.; Sonntag, N.O.V. Bailey’s Industrial Oil and Fat Products; Wiley: New York, NY, USA, 1982; ISBN 9780471839583. [Google Scholar]
- Mosiewicki, M.A.; Aranguren, M.I. A short review on novel biocomposites based on plant oil precursors. Eur. Polym. J. 2013, 49, 1243–1256. [Google Scholar] [CrossRef] [Green Version]
- Meier, M.A.R.; Metzger, J.; Schubert, U.S. Plant oil renewable resources as green alternatives in polymer science. Chem. Soc. Rev. 2007, 36, 1788–1802. [Google Scholar] [CrossRef] [PubMed]
- Wool, R.P. Biobased Polymers and Composites; Elsevier Academic Press: Burlington, VT, USA, 2005; ISBN 978-0-12-763952-9. [Google Scholar]
- Alam, M.; Akram, D.; Sharmin, E.; Zafar, F.; Ahmad, S. Vegetable oil based eco-friendly coating materials: A review article. Arab. J. Chem. 2014, 7, 469–479. [Google Scholar] [CrossRef]
- Xia, Y.; Zhang, Z.; Kessler, M.R.; Brehm-Stecher, B.; Larock, R.C. Antibacterial Soybean-Oil-Based Cationic Polyurethane Coatings Prepared from Different Amino Polyols. Chem. Sus. Chem. 2012, 5, 2221–2227. [Google Scholar] [CrossRef]
- Garrison, T.F.; Zhang, Z.; Kim, H.; Mitra, D.; Xia, Y.; Pfister, D.P.; Brehm-Stecher, B.; Larock, R.C.; Kessler, M.R. Thermo-Mechanical and Antibacterial Properties of Soybean Oil-Based Cationic Polyurethane Coatings: Effects of Amine Ratio and Degree of Crosslinking. Macromol. Mater. Eng. 2014, 299, 1042–1051. [Google Scholar] [CrossRef]
- Liang, H.; Liu, L.; Lu, J.; Chen, M.; Zhang, C. Castor oil-based cationic waterborne polyurethane dispersions: Storage stability, thermo-physical properties and antibacterial properties. Ind. Crops. Prod. 2018, 117, 169–178. [Google Scholar] [CrossRef]
- Wang, R.; Schuman, T.P. Vegetable oil-derived epoxy monomers and polymer blends: A comparative study with review. Express Polym. Lett. 2013, 7, 272–292. [Google Scholar] [CrossRef]
- Zhu, L.; Wool, R.P. Nanoclay reinforced bio-based elastomers: Synthesis and characterization. Polymer 2006, 47, 8106–8115. [Google Scholar] [CrossRef]
- Lu, Y.; Larock, R.C. Novel Biobased Nanocomposites from Soybean Oil and Functionalized Organoclay. Biomacromolecules 2006, 7, 2692–2700. [Google Scholar] [CrossRef] [PubMed]
- Díez-Pascual, A.M.; Díez-Vicente, A.L. Epoxidized Soybean Oil/ZnOBiocomposites for Soft Tissue Applications: Preparation and Characterization. ACS Appl. Mater. Interfaces 2014, 6, 17277–17288. [Google Scholar] [CrossRef] [PubMed]
- Díez-Pascual, A.M.; Díez-Vicente, A.L. Wound Healing Bionanocomposites Based on Castor Oil Polymeric Films Reinforced with Chitosan-Modified ZnO Nanoparticles. Biomacromolecules 2015, 16, 2631–2644. [Google Scholar] [CrossRef] [PubMed]
- Deka, H.; Karak, N.; Kalita, R.D.; Buragohain, A.K. Bio-based thermostable, biodegradable and biocompatible hyperbranched polyurethane/Ag nanocomposites with antimicrobial activity. Polym. Degrad. Stab. 2010, 95, 1509–1517. [Google Scholar] [CrossRef]
- Gold, K.; Slay, B.; Knackstedt, M.; Gaharwar, A.K. Antimicrobial Activity of Metal and Metal-Oxide Based Nanoparticles. Adv. Therap. 2018, 1, 1700033. [Google Scholar] [CrossRef]
- Seil, J.T.; Webster, T.J. Antimicrobial applications of nanotechnology: Methods and literature. Int. J. Nanomed. 2012, 2012, 2767–2781. [Google Scholar] [CrossRef]
- Brunner, T.J.; Wick, P.; Manser, P.; Spohn, P.; Grass, R.N.; Limbach, L.K.; Bruinink, A.; Stark, W.J. In Vitro Cytotoxicity of Oxide Nanoparticles: Comparison to Asbestos, Silica, and the Effect of Particle Solubility. Environ. Sci. Technol. 2006, 40, 4374–4381. [Google Scholar] [CrossRef]
- Díez-Pascual, A.M.; Xu, C.; Luque, R. Development and characterization of novel poly(ether ether ketone)/ZnObionanocomposites. J. Mater. Chem. B 2014, 2, 3065–3078. [Google Scholar] [CrossRef]
- Coleman, A.; Jagadish, C. Basic properties and applications of ZnO—Chapter 1. In Zinc Oxide Bulk, Thin Films and Nanostructures; Jagadish, C., Pearton, S., Eds.; Elsevier: Oxford, UK, 2006; pp. 1–20. ISBN 978-0-08-044722-3. [Google Scholar]
- Díez-Pascual, A.M.; Díez-Vicente, A.L. Development of Nanocomposites Reinforced with CarboxylatedPoly(ether ether ketone) Grafted to Zinc Oxide with Superior Antibacterial Properties. ACS Appl. Mater. Interfaces 2014, 6, 3729–3741. [Google Scholar] [CrossRef]
- Díez-Pascual, A.M.; Díez-Vicente, A.L. Poly(3-hydroxybutyrate)/ZnOBionanocomposites with Improved Mechanical, Barrier and Antibacterial Properties. Int. J. Mol. Sci. 2014, 15, 10950–10973. [Google Scholar] [CrossRef] [PubMed]
- Hajipour, M.J.; Fromm, K.M.; Akbar Ashkarran, A.; Jimenez de Aberasturi, D.; Larramendi, I.R.D.; Rojo, T.; Serpooshan, V.; Parak, W.J.; Mahmoudi, M. Antibacterial properties of nanoparticles. Trends Biotechnol. 2012, 30, 499–511. [Google Scholar] [CrossRef] [PubMed] [Green Version]
- Díez-Pascual, A.M.; Díez-Vicente, A.L. ZnO-Reinforced Poly(3-hydroxybutyrate-co-3-hydroxyvalerate) Bionanocomposites with Antimicrobial Function for Food Packaging. ACS Appl. Mater. Interfaces 2014, 6, 9822–9834. [Google Scholar] [CrossRef] [PubMed]
- Zheng, K.; Setyawati, M.I.; Leong, D.T.; Xie, J. Antimicrobial Gold Nanoclusters. ACS Nano 2017, 11, 6904–6910. [Google Scholar] [CrossRef]
- Padmavathy, N.; Vijayaraghavan, R. Enhanced bioactivity of ZnO nanoparticles-an antimicrobial study. Sci. Technol. Adv. Mater. 2008, 9, 035004. [Google Scholar] [CrossRef]
- Díez-Pascual, A.M.; Díez-Vicente, A.L. High-Performance Aminated Poly(phenylene sulfide)/ZnO Nanocomposites for Medical Applications. ACS Appl. Mater. Interfaces 2014, 6, 10132–10145. [Google Scholar] [CrossRef] [Green Version]
- Díez-Pascual, A.M.; Díez-Vicente, A.L. Effect of TiO2 nanoparticles on the performance of polyphenylsulfone biomaterial for orthopaedic implants. J. Mater. Chem. B 2014, 2, 7502–7514. [Google Scholar] [CrossRef]
- Pelaez, M.; Nolan, N.T.; Pillai, S.C.; Seery, M.K.; Falaras, P.; Kontos, A.G.; Dunlop, P.S.M.; Hamilton, J.W.J.; Byrne, J.A.; O’Shea, K.; et al. A review on the visible light active titanium dioxide photocatalysts for environmental applications. Appl. Catal. B 2012, 125, 331–349. [Google Scholar] [CrossRef] [Green Version]
- Fadeel, B.; Garcia-Bennett, A.E. Better safe than sorry: Understanding the toxicological properties of inorganic nanoparticles manufactured for biomedical applications. Adv. Drug Deliv. Rev. 2010, 62, 362–374. [Google Scholar] [CrossRef]
- Díez-Pascual, A.M.; Díez-Vicente, A.L. Nano-TiO2 Reinforced PEEK/PEI Blends as Biomaterials for Load-Bearing Implant Applications. ACS Appl. Mater. Interfaces 2015, 7, 5561–5573. [Google Scholar] [CrossRef]
- Galib, M.B.; Mashru, M.; Jagtap, C.; Patgiri, B.J.; Prajapati, P.K. Therapeutic potentials of metals in ancient India: A review through Charaka Samhita. J. Ayurveda Inter. Med. 2011, 2, 55–63. [Google Scholar] [CrossRef] [PubMed] [Green Version]
- Allahverdiyev, A.M.; Kon, K.V.; Abamor, E.S.; Bagirova, M.; Rafailovich, M. Coping with antibiotic resistance: Combining nanoparticles with antibiotics and other antimicrobial agents. Expert Rev. Anti InfecyTher. 2011, 9, 1035–1052. [Google Scholar] [CrossRef] [PubMed]
- Magdolenova, Z.; Collins, A.; Kumar, A.; Dhawan, A.; Stone, V.; Dusinska, M. Mechanisms of genotoxicity. A review of in vitro and in vivo studies with engineered nanoparticles. Nanotoxicology 2014, 8, 233–278. [Google Scholar] [CrossRef] [PubMed]
- Richardson, H.W. Copper Compounds. In Ullmann’s Encyclopedia of Industrial Chemistry; Wiley-VCH: Weinheim, Germany, 2000; ISBN 9783527303854. [Google Scholar]
- Moreno, J.L.V.; Padama, A.A.B.; Kasai, H. A density functional theory-based study on the dissociation of NO on a CuO(110) surface. Cryst. Eng. Comm. 2014, 16, 2260–2265. [Google Scholar] [CrossRef]
- Angelé-Martínez, C.; Nguyen, K.V.T.; Ameer, F.S.; Anker, J.N.; Brumaghim, J.L. Reactive oxygen species generation by copper(II) oxide nanoparticles determined by DNA damage assays and EPR spectroscopy. Nanotoxicology 2017, 11, 278–288. [Google Scholar] [CrossRef] [Green Version]
- Yamamoto, K.; Kawanishi, S. Hydroxyl free radical is not the main active species in site-specific DNA damage induced by copper (II) ion and hydrogen peroxide. J. Biol. Chem. 1989, 264, 15435–15440. [Google Scholar]
- Blaney, L. Magnetite (Fe3O4): Properties, Synthesis, and Applications. Lehigh Rev. 2007, 15, 5. [Google Scholar]
- Xiaodi, L.; Zhiguo, Z.; Yufeng, T.; Bingyu, L. Review on the Synthesis and Applications of Fe3O4 Nanomaterials. J. Nanomater. 2013, 2013, 902538. [Google Scholar] [CrossRef]
- Arakha, M.; Pal, S.; Samantarrai, D.; Panigrahi, T.K.; Mallick, B.C.; Pramanik, K.; Mallick, B.; Jha, S. Antimicrobial activity of iron oxide nanoparticle upon modulation of nanoparticle-bacteria interface. Sci. Rep. 2015, 5, 14813. [Google Scholar] [CrossRef] [Green Version]
- Díez-Pascual, A.M.; Díez-Vicente, A.L. Development of linseed oil–TiO2 green nanocomposites as antimicrobial coatings. J. Mater. Chem. B 2015, 3, 4458–4471. [Google Scholar] [CrossRef]
- Al-Jumaili, A.; Mulvey, P.; Kumar, A.; Prasad, K.; Bazaka, K.; Warner, J.; Jacob, M.V. Eco-friendly nanocomposites derived from geranium oil and zinc oxide in one step approach. Sci. Rep. 2019, 9, 5973. [Google Scholar] [CrossRef] [PubMed]
- Das, B.; Mandal, M.; Upadhyay, A.; Chattopadhyay, P.; Karak, N. Bio-based hyperbranched polyurethane/Fe3O4nanocomposites: Smart antibacterial biomaterials for biomedical devices and implants. Biomed. Mater. 2013, 8, 035003. [Google Scholar] [CrossRef] [PubMed]
- Das, B.; Chattopadhyay, P.; Upadhyay, A.; Gupta, K.; Mandal, M.; Karak, N. Biophysico-chemical interfacial attributes of Fe3O4 decorated MWCNT nanohybrid/bio-based hyperbranched polyurethane nanocomposite: An antibacterial wound healing material with controlled drug release potential. N. J. Chem. 2014, 38, 4300–4311. [Google Scholar] [CrossRef]
- Sharmin, E.; Zafar, F.; Akram, D.; Ahmad, S. Plant oil polyol nanocomposite for antibacterial polyurethane coating. Prog. Org. Coat. 2013, 76, 541–547. [Google Scholar] [CrossRef]
- Bazaka, K.; Jacob, M.; Truong, V.K.; Crawford, R.J.; Ivanova, E.P. The Effect of Polyterpenol Thin Film Surfaces on Bacterial Viability and Adhesion. Polymers 2011, 3, 388–404. [Google Scholar] [CrossRef] [Green Version]
- Bazaka, K.; Bazaka, O.; Levchenko, I.; Xu, S.; Ivanova, E.P.; Keidar, M.; Ostrikov, K. Plasma-potentiated small molecules—Possible alternative to antibiotics? Nano Futures 2017, 1, 025002. [Google Scholar] [CrossRef]
- Prasad, K.; Lekshmi, G.S.; Ostrikov, K.; Lussini, V.; Blinco, J.; Mohandas, M.; Vasilev, K.; Bottle, S.; Bazaka, K.; Ostrikov, K. Synergic bactericidal effects of reduced graphene oxide and silver nanoparticles against Gram-positive and Gram-negative bacteria. Sci. Rep. 2017, 7, 1591. [Google Scholar] [CrossRef]
- Sinha, R.; Karan, R.; Sinha, A.; Khare, S.K. Interaction and nanotoxic effect of ZnO and Ag nanoparticles on mesophilic and halophilic bacterial cells. Bioresour. Technol. 2011, 102, 1516–1520. [Google Scholar] [CrossRef]
- Arakha, M.; Saleem, M.; Mallick, B.C.; Jha, S. The effects of interfacial potential on antimicrobial propensity of ZnO nanoparticle. Sci. Rep. 2015, 5, 9578. [Google Scholar] [CrossRef]
- Desbois, A.; Smith, V. Antibacterial free fatty acids: Activities, mechanisms of action and biotechnological potential. Appl. Microbiol. Biotechnol. 2010, 85, 1629–1642. [Google Scholar] [CrossRef]
- Betancourt-Galindo, R.; Berlanga Duarte, M.L.; Puente Urbina, B.A.; Rodríguez-Fernández, O.S.; Sánchez-Valdés, S. Surface Modification of ZnO Nanoparticles. Mater. Sci Forum 2010, 644, 61–64. [Google Scholar] [CrossRef]
- Rabea, E.I.; Badawy, M.E.; Stevens, C.V.; Smagghe, G.; Steurbaut, W. Chitosan as Antimicrobial Agent: Applications and Mode of Action. Biomacromolecules 2003, 4, 1457–1465. [Google Scholar] [CrossRef] [PubMed]
- Chung, Y.; Chen, C. Antibacterial characteristics and activity of acid-soluble chitosan. Bioresour. Technol. 2008, 99, 2806–2814. [Google Scholar] [CrossRef] [PubMed]
- Archana, D.; Dutta, J.; Dutta, P.K. Evaluation of chitosan nano dressing for wound healing: Characterization, in vitro and in vivo studies. Int. J. Biol. Macromol. 2013, 57, 193–203. [Google Scholar] [CrossRef] [PubMed]
- Archana, D.; Singh, B.K.; Dutta, J.; Dutta, P.K. In vivo evaluation of chitosan–PVP–titanium dioxide nanocomposite as wound dressing material. Carbohyd. Polym. 2013, 95, 530–539. [Google Scholar] [CrossRef] [PubMed]
- Archana, D.; Singh, B.K.; Dutta, J.; Dutta, P.K. Chitosan-PVP-nano silver oxide wound dressing: In vitro and in vivo evaluation. Int. J. Biol. Macromol. 2015, 73, 49–57. [Google Scholar] [CrossRef]
- Amin, K.A.M.; Panhuis, M.I.H. Reinforced Materials Based on Chitosan, TiO2 and Ag Composites. Polymers 2012, 4, 590–599. [Google Scholar] [CrossRef] [Green Version]
- Dhillon, G.; Kaur, S.; Brar, S. Facile fabrication and characterization of chitosan-based zinc oxide nanoparticles and evaluation of their antimicrobial and antibiofilm activity. Int. Nano Lett. 2014, 4, 1–11. [Google Scholar] [CrossRef]
- Bakhshi, H.; Yeganeh, H.; Mehdipour-Ataei, S.; Shokrgozar, M.; Yari, A.; Seyyed, N. Synthesis and characterization of antibacterial polyurethane coatings from quaternary ammonium functionalized soybean oil based polyols. Mater. Sci. Eng. C 2013, 33, 153–164. [Google Scholar] [CrossRef]
- Díez-Pascual, A.M.; Díez-Vicente, A.L. Poly(propylene fumarate)/Polyethylene Glycol-Modified Graphene Oxide Nanocomposites for Tissue Engineering. ACS Appl. Mater. Interfaces 2016, 8, 17902–17914. [Google Scholar] [CrossRef]
- Díez-Pascual, A.M.; Díez-Vicente, A.L. PEGylated boron nitride nanotube-reinforced poly(propylene fumarate) nanocomposite biomaterials. RSC Adv. 2016, 6, 79507–79519. [Google Scholar] [CrossRef]
- Muñoz-Bonilla, A.; Cerrada, M.L.; Fernandez-Garcia, M. Introduction to Polymeric Antimicrobial Materials. Chapter 1. In Polymeric Materials with Antimicrobial Activity: From Synthesis to Applications; RSC Publishing: Oxford, UK, 2014; p. 311. ISBN 978-1-84973-807-1. [Google Scholar]
- Wu, J.; Li, C.; Tsai, C.; Chou, C.; Chen, D.; Wang, G. Synthesis of antibacterial TiO2/PLGA composite biofilms. Nanomed. Nanotechnol. 2014, 10, e1097–e1107. [Google Scholar] [CrossRef] [PubMed]
- Cho, M.; Chung, H.; Choi, W.; Yoon, J. Linear correlation between inactivation of E. coli and OH radical concentration in TiO2 photocatalytic disinfection. Water Res. 2004, 38, 1069–1077. [Google Scholar] [CrossRef] [PubMed]
- Nadtochenko, V.; Denisov, N.; Sarkisov, O.; Gumy, D.; Pulgarin, C.; Kiwi, J. Laser kinetic spectroscopy of the interfacial charge transfer between membrane cell walls of E. coli and TiO2. J. Photoch. Photobio. A 2006, 181, 401–407. [Google Scholar] [CrossRef]
- Zielecka, M.; Bujnowska, E.; Kępska, B.; Wenda, M.; Piotrowska, M. Antimicrobial additives for architectural paints and impregnates. Prog. Org. Coat. 2011, 72, 193–201. [Google Scholar] [CrossRef]
- Turkoglu, A.; Duru, M.E.; Mercan, N.; Kivrak, I.; Gezer, K. Antioxidant and antimicrobial activities of Laetiporussulphureus (Bull.) Murrill. Food Chem. 2007, 101, 267–273. [Google Scholar] [CrossRef]
- Martí, M.; Frígols, B.; Serrano-Aroca, A. Antimicrobial Characterization of Advanced Materials for Bioengineering Applications. J. Vis. Exp. 2018, 138, e57710. [Google Scholar] [CrossRef]
- Pramanik, S.; Konwarh, R.; Deka, R.C.; Aidew, L.; Barua, N.; Buragohain, A.K.; Mohanta, D.; Karak, N. Microwave-assisted poly (glycidyl methacrylate)-functionalized multiwall carbon nanotubes with a ‘tendrillar’ nanofibrous polyaniline wrapping and their interaction at bio-interface. Carbon 2013, 55, 34–43. [Google Scholar] [CrossRef]
- Jackson, P.; Jacobsen, N.R.; Baun, A.; Birkedal, R.; Kühnel, D.; Jensen, K.A.; Vogel, U.; Wallin, H. Bioaccumulation and ecotoxicity of carbon nanotubes. Chem. Cent. J. 2013, 7, 154. [Google Scholar] [CrossRef]
- Arias, L.R.; Yang, L. Inactivation of bacterial pathogens by carbon nanotubes in suspensions. Langmuir 2009, 25, 3003–3012. [Google Scholar] [CrossRef]

| Fatty Acid | Formula | Structure |
|---|---|---|
| Palmitic | C16H32O2 |  |
| Palmitoleic | C16H30O2 |  |
| Stearic | C18H36O2 |  |
| Oleic | C18H34O2 |  |
| Linoleic | C18H32O2 |  |
| Linolenic | C18H30O2 |  |
| α-Eleostearic | C18H30O2 |  |
| Vegetable Oil | Double Bonds a | Iodine Value b (mg/100g) | Fatty Acids (%) | ||||
|---|---|---|---|---|---|---|---|
| Palmitic | Stearic | Oleic | Linoleic | Linolenic | |||
| Palm | 1.7 | 44–58 | 42.8 | 4.2 | 40.5 | 10.1 | - |
| Olive | 2.8 | 75–94 | 13.7 | 2.5 | 71.1 | 10.0 | 0.6 |
| Groundnut | 3.4 | 80–106 | 11.4 | 2.4 | 48.3 | 31.9 | - |
| Rapeseed | 3.8 | 94–120 | 4.0 | 2.0 | 56.0 | 26.0 | 10 |
| Sesame | 3.9 | 103–116 | 9.0 | 6.0 | 41.0 | 43.0 | 1.0 |
| Cottonseed | 3.9 | 90–119 | 21.6 | 2.6 | 18.6 | 54.4 | 0.7 |
| Corn | 4.5 | 102–130 | 10.9 | 2.0 | 25.4 | 59.6 | 1.2 |
| Soybean | 4.6 | 117–143 | 11.0 | 4.0 | 23.4 | 53.3 | 7.8 |
| Sunflower | 4.7 | 110–143 | 5.2 | 2.7 | 37.2 | 53.8 | 1.0 |
| Castor c | 4.8 | 83–88 | 1.3 | 1.2 | 4.0 | 5.2 | 0.3 |
| Linseed | 6.6 | 168–204 | 5.5 | 3.5 | 19.1 | 15.3 | 56 |
| Nanocomposite Type (Processing) | Antibacterial Activity (AU) | Bacteria Strain | Average NP Size (nm) | NP Shape | NP Concentration (wt %) | REF |
|---|---|---|---|---|---|---|
| Zn/Ge 10 (PP) | 31 a | S. aureus | 60 | Ball-like | 0.79 | 47 |
| Zn/Ge 10 (PP) | 33 a | E. coli | 60 | Ball-like | 0.79 | 47 |
| Zn/Ge 50 (PP) | 42 a | S. aureus | 80 | Ball-like | 1.57 | 47 |
| Zn/Ge 50 (PP) | 44 a | E. coli | 80 | Ball-like | 1.57 | 47 |
| ESO/ZnO (SM + C) | 0.30 | E. coli | 65 | Spherical | 1.00 | 17 |
| ESO/ZnO (SM + C) | 0.55 | S. aureus | 65 | Spherical | 1.00 | 17 |
| ESO/ZnO (SM + C) | 0.60 | E. coli | 73 | Spherical | 3.00 | 17 |
| ESO/ZnO (SM + C) | 0.98 | S. aureus | 73 | Spherical | 3.00 | 17 |
| ESO/ZnO (SM + C) | 1.12 | E. coli | 80 | Spherical | 5.00 | 17 |
| ESO/ZnO (SM + C) | 1.47 | S. aureus | 80 | Spherical | 5.00 | 17 |
| ESO/ZnO (SM + C) | 1.32 | E. coli | 92 | Spherical | 7.00 | 17 |
| ESO/ZnO (SM + C) | 1.68 | S. aureus | 92 | Spherical | 7.00 | 17 |
| AELO/TiO2 (IP + C) | 0.41 | E. coli | 40 | Spherical | 1.00 | 46 |
| AELO/TiO2 (IP + C) | 0.60 | S. aureus | 40 | Spherical | 1.00 | 46 |
| AELO/TiO2 (IP + C) | 1.12 | E. coli | 42 | Spherical | 2.50 | 46 |
| AELO/TiO2 (IP + C) | 1.62 | S. aureus | 42 | Spherical | 2.50 | 46 |
| AELO/TiO2 (IP + C) | 1.73 | E. coli | 46 | Spherical | 5.00 | 46 |
| AELO/TiO2 (IP + C) | 2.68 | S. aureus | 46 | Spherical | 5.00 | 46 |
| AELO/TiO2 (IP + C) | 1.92 | E. coli | 64 | Spherical | 7.50 | 46 |
| AELO/TiO2 (IP + C) | 2.81 | S. aureus | 64 | Spherical | 7.50 | 46 |
| CO/CS-ZnO (SM + C) | 0.75 | E. coli | 168 | Quasi-spherical | 1.00 | 18 |
| CO/CS-ZnO (SM + C) | 1.20 | S. aureus | 168 | Quasi-spherical | 1.00 | 18 |
| CO/CS-ZnO (SM + C) | 1.10 | M. luteus | 168 | Quasi-spherical | 1.00 | 18 |
| CO/CS-ZnO (SM + C) | 0.98 | E. coli | 177 | Quasi-spherical | 2.50 | 18 |
| CO/CS-ZnO (SM + C) | 1.80 | S. aureus | 177 | Quasi-spherical | 2.50 | 18 |
| CO/CS-ZnO (SM + C) | 1.71 | M. luteus | 177 | Quasi-spherical | 2.50 | 18 |
| CO/CS-ZnO (SM + C) | 1.32 | E. coli | 175 | Quasi-spherical | 5.00 | 18 |
| CO/CS-ZnO (SM + C) | 2.30 | S. aureus | 175 | Quasi-spherical | 5.00 | 18 |
| CO/CS-ZnO (SM + C) | 2.24 | M. luteus | 175 | Quasi-spherical | 5.00 | 18 |
| CO/CS-ZnO (SM + C) | 1.55 | E. coli | 180 | Quasi-spherical | 7.50 | 18 |
| CO/CS-ZnO (SM + C) | 3.05 | S. aureus | 180 | Quasi-spherical | 7.50 | 18 |
| CO/CS-ZnO (SM + C) | 2.98 | M. luteus | 180 | Quasi-spherical | 7.50 | 18 |
| LO/CuO (SL) | 17 b | E. coli | 50 | Quasi-spherical | 0.04 c | 50 |
| LO/CuO (SL) | 55 b | S. aureus | 50 | Quasi-spherical | 0.04 c | 50 |
| LO/CuO (SL) | 24 b | E. coli | 56 | Quasi-spherical | 0.05 c | 50 |
| LO/CuO (SL) | 57b | S. aureus | 56 | Quasi-spherical | 0.05 c | 50 |
| LO/CuO (SL) | 62 b | E. coli | 59 | Quasi-spherical | 0.06 c | 50 |
| LO/CuO (SL) | 60 b | S. aureus | 59 | Quasi-spherical | 0.06 c | 50 |
| HBPU/Fe3O4 (SC + C) | 0.43d | S. aureus | 9 | Spherical | 15.0 | 48 |
| HBPU/Fe3O4 (SC + C) | 0.42 d | K. pneu-moniae | 9 | Spherical | 15.0 | 48 |
| HBPU/Fe3O4-CNT (SC + C) | 0.40 d | S. aureus | 11 | Spherical | 15.0 | 49 |
| HBPU/Fe3O4-CNT (SC + C) | 0.39 d | K. pneu-moniae | 11 | Spherical | 15.0 | 49 |
© 2019 by the author. Licensee MDPI, Basel, Switzerland. This article is an open access article distributed under the terms and conditions of the Creative Commons Attribution (CC BY) license (http://creativecommons.org/licenses/by/4.0/).
Share and Cite
Diez-Pascual, A.M. Antibacterial Nanocomposites Based on Thermosetting Polymers Derived from Vegetable Oils and Metal Oxide Nanoparticles. Polymers 2019, 11, 1790. https://doi.org/10.3390/polym11111790
Diez-Pascual AM. Antibacterial Nanocomposites Based on Thermosetting Polymers Derived from Vegetable Oils and Metal Oxide Nanoparticles. Polymers. 2019; 11(11):1790. https://doi.org/10.3390/polym11111790
Chicago/Turabian StyleDiez-Pascual, Ana Maria. 2019. "Antibacterial Nanocomposites Based on Thermosetting Polymers Derived from Vegetable Oils and Metal Oxide Nanoparticles" Polymers 11, no. 11: 1790. https://doi.org/10.3390/polym11111790





